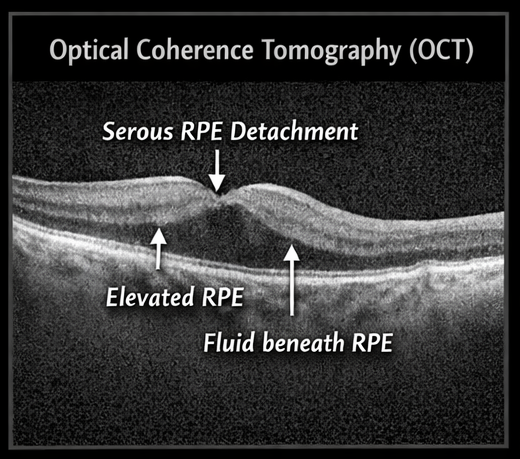

Retinal pigment epithelium (RPE) detachment is a clinically significant ophthalmic condition characterized by separation of the RPE from the underlying Bruch’s membrane, resulting from accumulation of fluid, blood, or drusenoid material. It is commonly associated with age-related macular degeneration (AMD) and central serous chorioretinopathy (CSCR), though other etiologies exist. Patients typically present with blurred vision, metamorphopsia, or central scotoma. Diagnosis relies heavily on multimodal imaging, particularly optical coherence tomography (OCT), fundus fluorescein angiography (FFA), and, when indicated, indocyanine green angiography (ICG). This case report describes a 52-year-old male presenting with symptomatic serous RPE detachment. It highlights the clinical presentation, diagnostic approach, management strategy, and favorable visual outcome following conservative treatment and close monitoring.
Retinal pigment epithelium detachment (PED) refers to the anatomical separation of the retinal pigment epithelium from Bruch’s membrane due to the accumulation of material in the sub-RPE space. PEDs are broadly categorized into serous, drusenoid, fibrovascular, and hemorrhagic types, each reflecting distinct pathophysiological mechanisms and clinical implications.
The condition is most frequently encountered in association with age-related macular degeneration, particularly in older adults, but may also occur in central serous chorioretinopathy, polypoidal choroidal vasculopathy, inflammatory chorioretinal disorders, and rarely, neoplastic conditions. Advances in retinal imaging, especially spectral-domain OCT, have revolutionized the diagnosis and monitoring of PEDs, allowing for precise morphological characterization and risk stratification.
Understanding the underlying etiology of PED is crucial, as it directly influences management decisions and prognosis. While serous PEDs may resolve spontaneously, fibrovascular PEDs often require active intervention due to their association with choroidal neovascularization (CNV).
Patient History
A 52-year-old male presented to the ophthalmology outpatient department with complaints of progressive blurring of central vision in the right eye over the past three weeks. He also reported mild distortion of objects (metamorphopsia), particularly noticeable while reading or using digital screens.
The onset was insidious, with gradual worsening. There were no complaints of pain, redness, flashes, or floaters. The patient had a known history of hypertension, which was well controlled on medication. There was no history of diabetes mellitus, corticosteroid use, or recent systemic illness.
He denied smoking and alcohol use and reported no prior ocular surgeries or trauma. There was no family history of retinal disease.
Visual Acuity
• Right eye (OD): 6/18
• Left eye (OS): 6/6
Anterior Segment Examination
• Within normal limits in both eyes
Intraocular Pressure
• Normal in both eyes
Fundus Examination
• Right eye: A well-defined, dome-shaped elevation in the macular region with a smooth contour and subtle yellowish appearance
• Left eye: Normal fundus

The macular elevation suggested an underlying RPE or subretinal pathology.
Differential Diagnosis
Based on the presenting features, the following differential diagnoses were considered:
• Central serous chorioretinopathy (CSCR)
• Non-neovascular (serous) PED
• Neovascular age-related macular degeneration
• Polypoidal choroidal vasculopathy
• Choroidal mass lesion (less likely)
Given the absence of hemorrhage and the patient’s clinical profile, a serous PED was considered most likely.
Optical Coherence Tomography (OCT)
OCT revealed:
• A dome-shaped elevation of the RPE layer
• Hyporeflective space beneath the RPE indicating fluid accumulation
• Intact overlying neurosensory retina
• No subretinal hyperreflective material suggestive of CNV
These findings were consistent with serous RPE detachment.
Fundus Fluorescein Angiography (FFA)
FFA findings included:
• Early pooling of fluorescein dye in the sub-RPE space
• No progressive leakage or late staining indicative of neovascularization
This helped rule out neovascular AMD.

Indocyanine Green Angiography (ICG) (if performed)
• No evidence of polypoidal lesions
• Choroidal circulation appeared normal

Serous retinal pigment epithelium detachment, likely secondary to central serous chorioretinopathy
Management and Outcome
Initial Management Strategy
Given the absence of CNV and relatively preserved visual acuity, a conservative approach was adopted.
Treatment Plan
Observation
• Regular follow-up with OCT imaging
• Self-monitoring using Amsler grid

Lifestyle Modifications
• Stress reduction through counseling and relaxation techniques
• Optimization of blood pressure control
• Avoidance of corticosteroids
4 Weeks
• Reduction in visual distortion
• Slight decrease in PED height on OCT

8 Weeks
• Visual acuity improved to 6/12
• Significant reduction in sub-RPE fluid
12 Weeks
• Visual acuity improved to 6/9
• Near-complete resolution of PED
• No evidence of CNV or recurrence
The patient demonstrated a favorable outcome with conservative management.
RPE detachment represents a spectrum of retinal disorders involving disruption of the RPE-Bruch’s membrane interface. The pathophysiology varies depending on the underlying condition. In CSCR, increased choroidal vascular permeability leads to accumulation of serous fluid beneath the RPE. In contrast, in AMD, degenerative changes and neovascularization play a dominant role.
Distinguishing between serous and fibrovascular PED is essential, as the latter carries a higher risk of progression and vision loss. OCT plays a pivotal role in differentiation, with fibrovascular PED often showing irregular elevations and internal reflectivity.
Etiology and Risk Factors
• Central serous chorioretinopathy
• Age-related macular degeneration
• Hypertension
• Corticosteroid exposure
• Psychological stress
Clinical Features
• Blurred central vision
• Metamorphopsia
• Central scotoma (in advanced cases)
• Often unilateral presentation
• OCT: Gold standard for detection and monitoring
• FFA: Differentiates leakage patterns
• ICG: Useful in identifying polypoidal lesions
Management Strategies
1. Conservative Approach
• Observation for serous PED
• Lifestyle modification
2. Pharmacological Therapy
• Anti-VEGF injections for neovascular PED
• Mineralocorticoid receptor antagonists in selected CSCR cases
3. Interventional Therapy
• Photodynamic therapy (PDT) in chronic or recurrent cases
Complications and Prognosis
Possible complications include:
• Development of choroidal neovascularization
• RPE tear
• Persistent visual impairment
Serous PED generally has a good prognosis, especially with early detection and appropriate monitoring.
Retinal pigment epithelium detachment is an important clinical entity requiring careful evaluation and differentiation of underlying causes. Multimodal imaging plays a central role in diagnosis and management. In cases of serous PED, conservative management with close follow-up can lead to favorable visual outcomes. Early detection and regular monitoring are essential to prevent complications and ensure optimal patient care.
Daruich A, et al. Central serous chorioretinopathy: Pathophysiology and management https://pubmed.ncbi.nlm.nih.gov/27825715/
American Academy of Ophthalmology – Age-related macular degeneration https://www.aao.org/eye-health/diseases/amd-macular-degeneration
Read more such content on @ Hidoc Dr | Medical Learning App for Doctors
1.
Contradictory Results Are Found in Two Pembrolizumab Trials for Head and Neck Cancer.
2.
Appropriate New Monoclonal for Immunocompromised Individuals to Prevent COVID-19.
3.
In myelofibrosis, combinations of rufolitinib reduce spleen volume.
4.
Adjuvant therapy for hepatocellular carcinoma after curative treatment: Several unanswered questions
5.
Obesity linked to subsequent neoplasms in childhood cancer survivors
1.
Unveiling the Hidden Benefits of Lymphedema Treatment
2.
The New Frontier of Cancer Survivorship: Navigating the Long-Term Effects of Immunotherapy and Targeted Therapies
3.
Managing High Potassium Levels: A Comprehensive Guide to Veltassa
4.
The Latest Research on Chronic Granulomatous Disease and Promising New Treatments
5.
Cold Antibody AIHA and Neoplastic Disorders: Unraveling the Clinical and Pathogenic Link
1.
International Lung Cancer Congress®
2.
Genito-Urinary Oncology Summit 2026
3.
Future NRG Oncology Meeting
4.
ISMB 2026 (Intelligent Systems for Molecular Biology)
5.
Annual International Congress on the Future of Breast Cancer East
1.
The Evolving Landscape of First-Line Treatment for Urothelial Carcinoma
2.
Current Scenario of Blood Cancer- Genomic Testing & Advancement in Diagnosis and Treatment
3.
The Landscape of First-Line Treatment for Urothelial Carcinoma- Further Discussion
4.
Efficient Management of First line ALK-rearranged NSCLC - Part VIII
5.
An In-Depth Look At The Signs And Symptoms Of Lymphoma
© Copyright 2026 Hidoc Dr. Inc.
Terms & Conditions - LLP | Inc. | Privacy Policy - LLP | Inc. | Account Deactivation